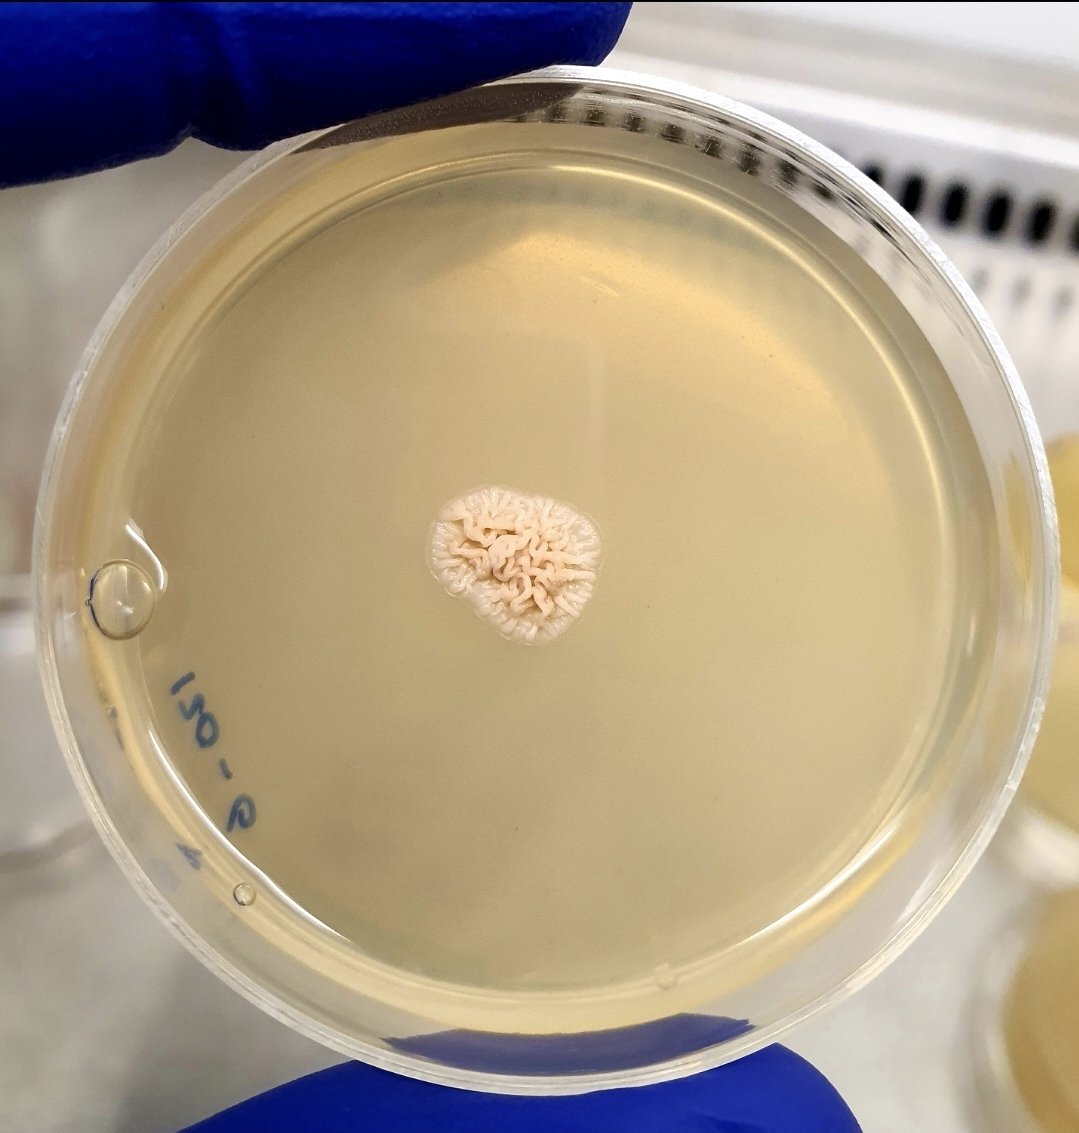
Aamer Kurdi tweet media
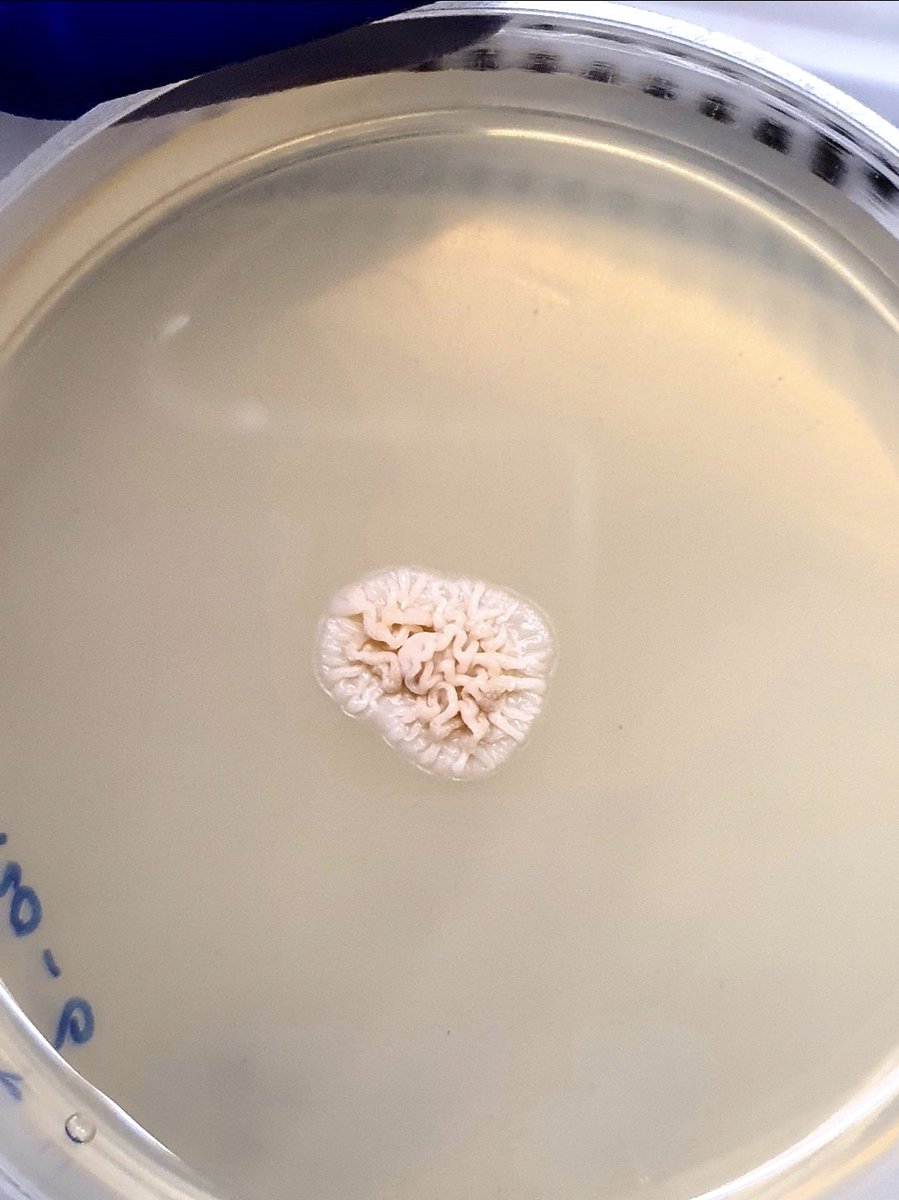
Aamer Kurdi tweet media

بِلقيس
593 posts



this is why I don't read webtoon wtf is this shit
nart (evil mart)@yournext2watch
???? Why is he horny while getting his hair cut?? 😭😭😭😭
English

@artopathic ما شفتيهم كانوا قالبين عالكويت عشان مانعين اي احد عنده باسبورت اسرائيلي يدخل😂
العربية

ماشاءالله الكسلوجيا عندنا متقدم بزياده
TRND@NOWTRND
ترند " مقطع متداول " فتاة تشارك: افضل روتين لمنطقة البكيني بتخلي ملمسه زي بشرة البيبي 👶🏻😍!
العربية

@dr_Ab4ullah @zzj778 @S_H_188 @SaudiMOH @HealthCo_sa يحبيبي الفلسطن بالكويت صاروا مع الجيش العراقي ما شفتوا شي انتوا
العربية

@zzj778 @S_H_188 @SaudiMOH @HealthCo_sa وش سالفتهم بالضبط بحرب الخليج
غير سوالف الأجانب اللي طلعو ورددو عبارات ضد المملكة العربيه السعودية واللي كانت "اضرب اضرب يا صدام من الخفجي الدمام"
العربية

شفنا كثير نماذج متكرره مثل هذي الحاله ومثبته في مواقع التواصل وهي "الاستهتار بالأزمات من مقيمين او اشخاص مقبلين عل طلب الإقامة"
لكن وش حلول وزارة الصحه ؟
كيف الشعب السعودي يضمن الامن والأمان وهو يُرى بهذي الطريقة ؟
@S_H_188 @SaudiMOH @HealthCo_sa
#الصحة_القابضة


العربية

@ZamoutWisam @binsaloomm @AlrougiR وقفنا التأشيرات وطردوهم من الوظايف الحكومية قبل شهرين بالكويت كان عندنا بعد نظر
العربية

@binsaloomm @AlrougiR مو الحق عليهم الحق عليكم
بتعرفوهن أعداء وفاتحين بلادكم الهن
العربية

الفلسطينيه بعد ماقدْفت ٦٠ بنت سعوديه
fatima 🇱🇧@xfatiimaaaa
بحياتي ما قربت صوب حدا ولا تدخلت بسيرة حدا، وبعيدة كل البعد عن المشاكل. حسابي مساحة إلي بنزل فيه يلي بدي وبحكي فيه كيف ما بدي، بلا ما استأذن من حدا ولا بنطر رضا حدا. و ما غلطت بحق اي شخص ولا تعدّيت ومع هيك فجأة بلاقي حالي داخلة بسيناريوهات ما إلي فيها ولا خصّني.
العربية